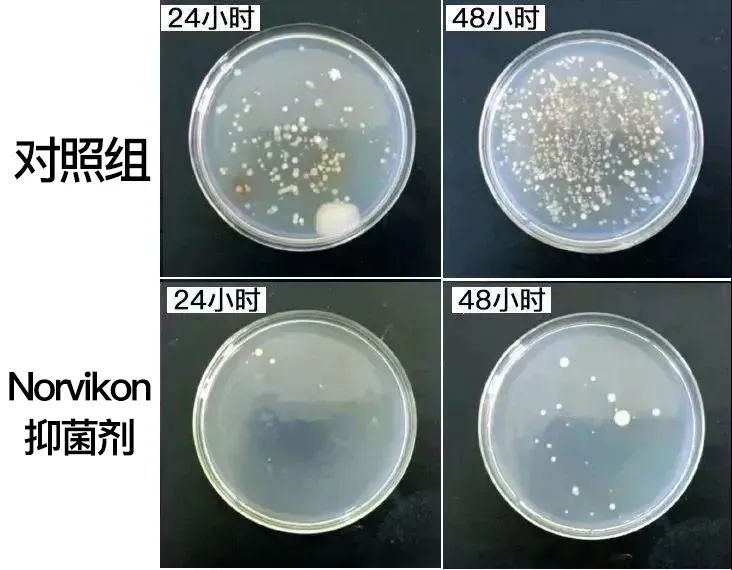

灰趾甲别用偏方了!简单一涂赶走灰指甲,恢复白嫩亮,持久不复发
2025年02月26日












01
美国原装进口
品质保证,安全可靠






02
循序渐进,逐步改善
可能很多人相信小广告





受益人一:李女士;白领;甲凹凸、甲发黄

我的脚特别会流汗,因为工作原因,夏天也不能穿凉鞋,去年指甲出了健康问题。起初只是指甲凹凸不平,到后来变黄变黑,怪吓人的,洗脚店都不敢去了。
这款产品是同事推荐的,他的指甲健康问题就是靠这个缓解的。
用了差不多一个月的颜色感觉就变淡了,凹凸不平的情况也缓解许多,两个月的时候,长出来的新指甲,就是健康的了,真的蛮惊喜的。
受益人二:畅畅;主妇;甲增厚,甲分离

身边的小姐妹,有空就会约起来去逛街,做做美甲,谁知道指甲健康问题找上门了,感觉难以接受!
还好有个姐妹的老公是专业人士,说这个产品靠谱,涂在指缝、甲床上面,吸收后就行,原来的旧甲就脱落了,长出来的指甲和食指健康的指甲一样。
受益人三:秦先生;退休;甲增厚,甲黑黄

灰指甲拖了好几年了,长出来的指甲都是黄色的,每次去看孙女都讨人嫌,产品用了一堆,土方子也试了,就是没效果。
这款产品是儿子给我买的,用下来感觉还不错,不好的指甲自己脱落了,新长出来的指甲都是肉色的。现在指甲好了,孙女跟我都亲近了。

第一步:草本成分 快速渗入,调节菌群

对微生物的抑制作用
第三方检测机构经过验证也出具了
权威的检测报告
对大肠杆菌、金黄色葡萄球菌、白色念珠菌
统统都有高达99.9%的抑制作用

第二步:形成洁净生物膜,隔离微生物

第三步:修护甲床,加快新指甲生长




限量优惠,戳图抢购▼








30623阅读
28赞
小来生活馆
